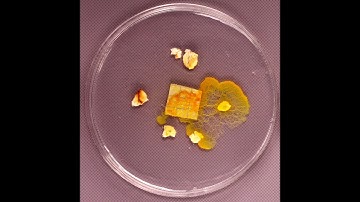
Time-lapse BLOB le sclérote se réveille

⬇ DOWNLOAD NOW
Kalau muncul iklan pop-up, tutup lalu klik tombol kembali
Download lagu Evolution d'un Blob en 6 heures secara gratis hanya untuk keperluan promosi. Dukung artis favorit kamu dengan membeli musik original di iTunes atau platform resmi lainnya.
 Pourquoi le blob fascine les scientifiques
Pourquoi le blob fascine les scientifiques
 Blob : les 3 premiers jours sur la pierre à blob
Blob : les 3 premiers jours sur la pierre à blob
 Evolution du blob deux heures après sa découverte.
Evolution du blob deux heures après sa découverte.
 Blob Time Lapse - Croissance d'un blob après alimentation. 2h de croissance en 15 secondes.
Blob Time Lapse - Croissance d'un blob après alimentation. 2h de croissance en 15 secondes.
 Mon Blob à la maison | Reportage CNRS
Mon Blob à la maison | Reportage CNRS
Time-lapse BLOB le sclérote se réveille
Time-lapse BLOB le sclérote se réveille
 Revivez le Big Blob Record !
Revivez le Big Blob Record !
 Blob sauvage trouvé dans une foret (9h de video accéleré)
Blob sauvage trouvé dans une foret (9h de video accéleré)